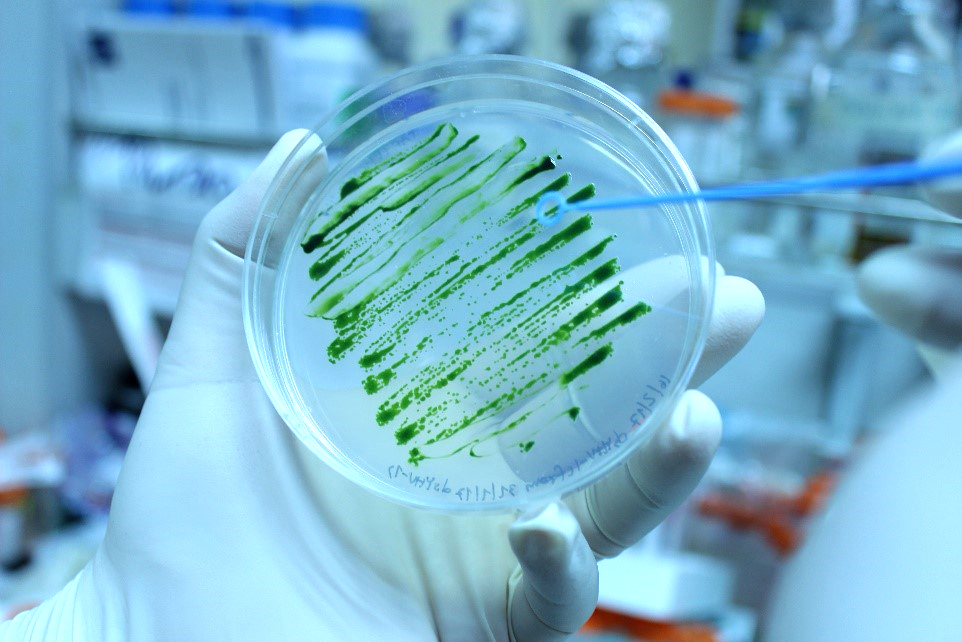
1

นักวิจัย ไบโอเทค สวทช. พัฒนาระบบเทคโนโลยีชีวภาพสาหร่ายเซลล์เดียวสำหรับใช้ควบคุมโรคกุ้งในภูมิภาคอาเซียน
กระทรวงการอุดมศึกษา วิทยาศาสตร์ วิจัยและนวัตกรรม (อว.) สำนักงานพัฒนาวิทยาศาสตร์และเทคโนโลยีแห่งชาติ (สวทช.) โดยศูนย์พันธุวิศวกรรมและเทคโนโลยีชีวภาพแห่งชาติ (ไบโอเทค) ร่วมกับ University of Kent พัฒนาวิธีการที่เกี่ยวข้องกับการใช้สาหร่ายเซลล์เดียว (microalgal-based platform) เพื่อการป้องกันโรคในอุตสาหกรรมการเลี้ยงกุ้งในประเทศไทย และประเทศในภูมิภาคเอเชียตะวันออกเฉียงใต้ โดยได้รับการสนับสนุนทุนวิจัย International Collaboration Awards 2019 จาก The Royal Society ภายใต้กรอบความร่วมมือ Global Challenges Research Fund (GCRF) สหราชอาณาจักร เป็นจำนวน 9 ล้านบาท ตั้งเป้านำเทคโนโลยีนี้ไปใช้ช่วยเหลือเกษตรกรผู้เลี้ยงกุ้งในการป้องกันการเกิดโรคตัวแดงดวงขาว และโรคหัวเหลืองได้ทั้งในประเทศไทยและระดับภูมิภาคอาเซียน
ในปี พ.ศ. 2562 รายงานจากสมาคมกุ้งไทยแสดงให้เห็นว่าประเทศไทยสามารถผลิตกุ้งเลี้ยงประมาณ 290,000 ตันต่อปี คิดเป็นมูลค่าประมาณ 48,000 ล้านบาท ซึ่งถือเป็นหนึ่งในอุตสาหกรรมที่มีมูลค่าการส่งออกสูงที่สุดของประเทศ อย่างไรก็ดี อุตสาหกรรมการเลี้ยงกุ้งได้รับผลกระทบอย่างต่อเนื่องจากจากการระบาดของโรคต่าง ๆ สร้างความสูญเสียมากถึง 60% ของผลผลิตในประเทศ และยังส่งผลกระทบต่ออุตสาหกรรมการเลี้ยงกุ้งในประเทศเพื่อนบ้านอีกด้วย การติดเชื้อไวรัสถือเป็นสาเหตุหลักที่ก่อให้เกิดการสูญเสียอย่างรุนแรงทางเศรษฐกิจ โดยเฉพาะการระบาดของโรคตัวแดงดวงขาว (White Spot Syndrome Virus - WSSV) และโรคหัวเหลือง (Yellow Head Virus-YHV) และข้อมูลจากกรมประมงเมื่อไม่นานมานี้พบว่า ยังคงมีการระบาดของไวรัสดังกล่าวอยู่อย่างต่อเนื่องในปัจจุบัน

ดร.วรรณวิมล ศักดิ์เสมอพรม นักวิจัยอาวุโส ทีมวิจัยเทคโนโลยีชีวภาพปลาและกุ้ง ไบโอเทค กล่าวว่า ระบบที่พัฒนาขึ้นนี้จะใช้เทคโนโลยีการแสดงออกของยีนแบบใหม่ในการผลิตอาร์เอ็นเอสายคู่ (double-stranded RNA; dsRNA) และการพัฒนาวัคซีนรีคอมบิแนนท์สำหรับใช้ผสมในอาหารเลี้ยงกุ้ง โดยใช้สาหร่ายเซลล์เดียว Chlamydomonas reinhardtii ซึ่งจากงานวิจัยที่ผ่านมาได้มีการทำงานร่วมกับ Prof. Colin Robinson ผู้เชี่ยวชาญจาก University of Kent โดยสามารถผลิตอาร์เอ็นเอสายคู่ในคลอโรพลาสต์ของสาหร่ายเซลล์เดียวนี้ ซึ่งมีประสิทธิภาพในการยับยั้งไวรัสหัวเหลืองผ่านการให้สาหร่ายลูกผสมเป็นอาหารเสริมแก่ลูกกุ้ง โดยมีแนวคิดจะพัฒนาระบบในการผลิตอาร์เอ็นเอและโปรตีนที่ช่วยยับยั้งโรคตัวแดงดวงขาวเพิ่มเติมต่อไป ซึ่งหากผลเป็นที่น่าพอใจ ก็จะสามารถนำเอาเทคโนโลยีนี้ไปใช้ช่วยเหลือเกษตรกรผู้เลี้ยงกุ้งในการป้องกันการเกิดโรคตัวแดงดวงขาว และโรคหัวเหลืองได้ทั้งในประเทศไทยและระดับภูมิภาคอาเซียน นอกจากนี้โครงการนี้ยังครอบคลุมถึงการศึกษาการใช้สารสกัดจากสาหร่ายเซลล์เดียวผสมในอาหารเลี้ยงกุ้ง เพื่อยับยั้งเชื้อไวรัสและแบคทีเรียหลายชนิด นำโดย ดร.อภิรดี หงส์ทอง นักวิจัยอาวุโส ทีมวิจัยชีวศาสตร์และชีววิทยาระบบ ไบโอเทค อีกด้วย
ทั้งนี้ ทุน GCRF International Collaboration Awards เป็นส่วนหนึ่งของโครงการพัฒนาประเทศกำลังพัฒนาของรัฐบาลสหราชอาณาจักร ซึ่งสนับสนุนโดยแหล่งทุน The Royal Society โดยเน้นการสนับสนุนความร่วมมือทางการวิจัยระหว่างนักวิจัยจากสหราชอาณาจักรและนักวิจัยจากประเทศกำลังพัฒนา เพื่อให้สามารถแก้ปัญหาสำคัญที่จำเพาะต่อภูมิภาคได้

![]()
- อว.พารับส่วนลด
- User Menu (Discount)
- แนะนำหน่วยงาน
- ภาพข่าวและกิจกรรม
กระทรวงการอุดมศึกษา วิทยาศาสตร์ วิจัยและนวัตกรรม (อว.)
เป็นหน่วยงานของรัฐที่จัดตั้งขึ้นเพื่อขับเคลื่อนการอุดมศึกษาไทย วิทยาศาสตร์ วิจัยและนวัตกรรม ไปสู่มาตรฐานในระดับสากล และเพิ่มอันดับความสามารถการแข่งขันในระดับนานาชาติอย่างยั่งยืน ไม่ได้มีวัตถุประสงค์เพื่อแสวงหากำไร หากท่านพบว่ามีข้อมูลใดๆ ที่ละเมิดทรัพย์สินทางปัญญาปรากฏอยู่ในเว็บไซต์นี้ โปรดแจ้งให้ทราบ เพื่อดำเนินการแก้ปัญหาดังกล่าวโดยเร็วที่สุดต่อไป
© 2020 Ministry of Higher Education, Science, Research and Innovation. ALL RIGHTS RESERVED.




